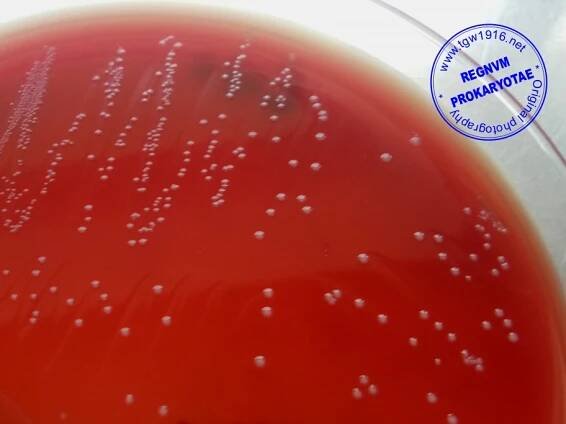
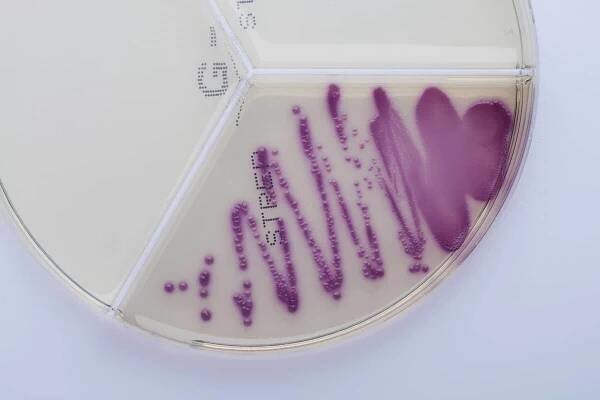
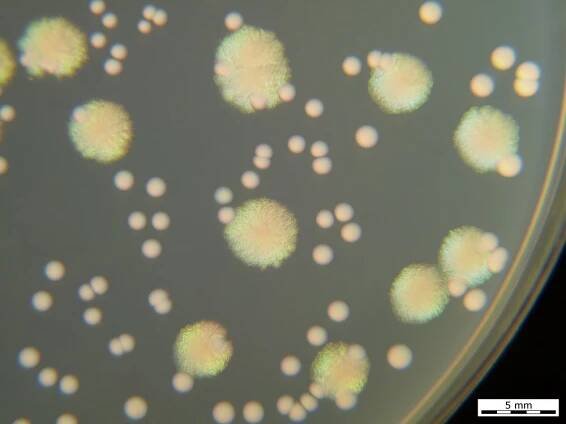

Enterococcus faecalis - Wikipedia
Enterococcus faecalis – formerly classified as part of the group D Streptococcus, is a Gram-positive, commensal bacterium naturally inhabiting the gastrointestinal tracts of humans. [1 ] [2 ] Like other species in the genus Enterococcus, E…
Enterokok (Enterococcus) je rozsáhlý rod bakterií mléčného kvašení z kmene Firmicutes. Jsou to grampozitivní koky, které se často vyskytují v párech či krátkých řetězcích. Jsou fakultativně anaerobní organismy - mohou žít v prostředí na kyslík jak chudém, tak bohatém.
Enterococcus faecalis - ClearMilkTest
Enterococcus faecalis: sektor Strep (streptokoky), malé kolonie fialové barvy, označeno č. 5; Staphylococcus succinus: sektor Stap (stafylokoky), malé jasně zelené kolonie, číslo 6; Serratia liquefaciens: sektor G- (gramnegativní tyčinky…
Enterococcus faecalis a jeho vliv na úspěšnost end…
Enterococcus faecalis je výrazně častěji izolován ze sekundárně ošetřovaných kořenových kanálků. Do kořenového systému zubu se dostává nejspíše přestupem z ústní dutiny během endodontického ošetření v důsledku nedostatečné kontroly asepse…
Enterococcus faecalis | uLékaře.cz
Dobrý den, při výtěru z vagíny mi vyšel pozitivní nález na Enterococcus faecalis, gynekolog mi nenasadil žádnou léčbu, prý je celkový nález negativní, není potřeba přeléčit Enterococcus faecalis ATB?
Enterococcus Faecalis | Dr. Max lékárna
Enterococcus faecalis patří mezi bakterie, které jsou v malých množstvích přítomny i v pochvách zdravých žen. V případě jejich přemnožení a úbytku obsahu laktobacilů v pochvě, může dojít k rozvoji bakteriální vaginózy.
Enterococcus faecalis | Dr. Max lékárna
Dobrý den, neustále mám bakterie v moči ( Enterococcus faecalis) které mi způsobují časté močení. Pan dr.na urologii mi předepisuje ATB cifloxinal 500, protože bohužel nemůžu penicilin.
Počet enterokoků
Enterococcus je druh bakterií, které se obvykle vyskytují ve střevech. V některých případech se tato bakterie vyskytuje také v ústech nebo vaginálním traktu. Pokud je přítomen u zdravých lidí nebo v normálním množství, enterok.
[Zodpovězené] Enterococcus faecalis. Co na pálení a jak často…
7. 10. 2019Dobrý deň, - I o tom se diskutuje na Modrém koníku. Přečti si zkušenosti a názory ostatních.
odkazuje na služby nejen od Seznam.cz.
© 1996–2025 Seznam.cz, a.s.